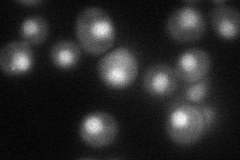
YDR416W
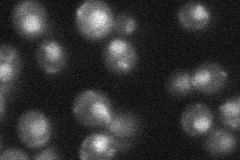
YDR416W
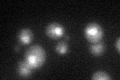
YDR416W
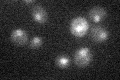
YDR416W

View description
Member of the NineTeen Complex (NTC) that contains Prp19p and stabilizes U6 snRNA in catalytic forms of the spliceosome containing U2, U5, and U6 snRNAs; null mutant has splicing defect and arrests in G2/M; homologs in human and C. elegans
Localization:
Intensity:
Fold change:
Significance:
-
C’ GFP library in SD

nucleus25.57 -
N' NOP1pr-GFP in SD

nucleus61.6143 -
N' TEF2pr-mCherry in SD
nucleus41.334 -
N' NATIVEpr-GFP in SD
nucleus27.6846 -
N' TEF2pr-VC and Cyto-VN in SD

#N/A0 -
C’ GFP library in SD+DTT
nucleus23.470.91No -
C’ GFP library in SD+H2O2

nucleus23.850.93No -
C’ GFP library in Starvation Media
nucleus20.670.8No -
C’ GFP library on the background of Pup2-DaMP

nucleus -
C’ GFP library on the background of CCT mutant

nucleus24.34540.951697No
